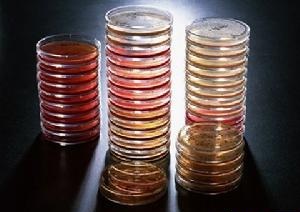

| 提交詢價信息 |
| 發(fā)布緊急求購 |

價格:電議
所在地:上海
型號:瓶
更新時間:2019-04-03
瀏覽次數:760
公司地址:上海市崇明縣長興鎮(zhèn)潘園公路1800號2號樓9703室
![]()
王靜(先生) 銷售經理
關于我們:
上海極威生物科技有限公司成立于上海,經過多年的努力發(fā)展已成為專業(yè)供應各類生物科研用品的公司,長期專注于生物領域,旗下產品種類眾多,特別是ELISA試劑盒這一產品已使極威生物成為業(yè)內知名公司。上海極威秉承以產品質量為根本,以市場需求為導向,以為客戶創(chuàng)造價值為己任的精神,致力于發(fā)展中國的科研事業(yè)。力求為我國生物科技事業(yè)提供更好的、更專業(yè)性的技術服務和科研產品。
主營業(yè)務:
公司目前主營的產品有ELISA試劑盒、生化試劑、標準品、對照品、抗體、細胞株、培養(yǎng)基、血清、酶、金標試劑盒、實驗耗材、進口試劑及實驗外包服務等。
應用領域:
公司產品在很多領域得到了廣泛的應用,涉及分子生物學、細胞生物學、免疫學等各個領域。為各大高校、醫(yī)院單位及各研究機構提供優(yōu)質的產品。并長期與各高校、研究機構、知名企業(yè)等建立了深厚的合作關系。
核心價值:
極力追求,科學權威!是上海極威永恒不變的宗旨;質量一,誠信為本!更是公司生存發(fā)展的基本原則。公司的核心價值是:以優(yōu)質的產品、實惠的價格、完善的服務,為我國生物科技事業(yè)提供更好的、更專業(yè)性的技術服務和科研產品;為樹立行業(yè)的領先地位而不懈努力,為科研事業(yè)及社會創(chuàng)造更多價值!
公司信息:
公司名稱:上海極威生物科技有限公司
訂購熱線:021-61843550
傳 真:021-61843550
詳細地址:上海市崇明縣長興鎮(zhèn)潘園公路1800號2號樓9703室
郵 編:202150
郵 箱:jiweibio@jiweibio.com
銷售客服:QQ:435893110 QQ:435399850
訂貨方式:
一、可直接來電向我司業(yè)務人員咨詢及訂購
二、可點擊本頁上方“QQ交談"與我司在線客服聯系
三、可發(fā)送咨詢郵件至我司郵箱,索取相關產品說明書
四、可在本頁下方留言,我司銷售人員會及時與您聯系
五、可在公司網站搜索相應產品名稱,聯系銷售人員訂購!
注:
一、由于產品種類較多,產品信息未能及時更新,如未在網上找到相應的產品,可直接電話或QQ上在線咨詢
二、訂購ELISA試劑盒的客戶,可享受免費代測服務,詳情咨詢相應銷售人員
付款信息:
戶 名:上海極威生物科技有限公司
開戶行:招商銀行股份有限公司上海虹橋支行
賬 戶:121917721110601
產品名稱:RV肉湯培養(yǎng)基
包裝規(guī)格:250g(具體規(guī)格可根據客戶需求定做)
產品用途:僅用于科研實驗,不得用于其他用途
一、RV肉湯培養(yǎng)基使用方法:見說明書
二、儲存條件及保質期
干粉培養(yǎng)基:2~8℃避光保存,用后立即旋緊瓶蓋。貯存期兩年。
配套試劑:2~8℃避光保存。貯存期兩年。
即用型平板:2~8℃避光保存,多一周。
脫水干粉:貯存于干燥處,避免陽光直射,用后立即旋緊瓶蓋。
未開封產品貯存期三年。
三、RV肉湯培養(yǎng)基注意事項
1、稱量時注意粉塵,佩戴口罩操作以避免引起呼吸道系統(tǒng)不適。
2、干粉培養(yǎng)基使用后立即旋緊瓶蓋,避免吸潮結塊。
3、自制平板時需注意培養(yǎng)基的厚度,厚度過薄容易造成瓊脂水分保持性下降,開裂;因此,一般需要15-20mL(Φ90mm)體積培養(yǎng)基,平板培養(yǎng)基厚度至少為2mm。
4、即用型成品平板應該盡量保持在2-8℃下保存且與存放容器冷凝管保持一定距離以避免凍損壞。產品多次在低溫與常溫之間變更會引起瓊脂的泌水,屬于正常現象。使用前應平衡至室溫且盡量在無菌干燥箱中預干燥。
四、RV肉湯培養(yǎng)基廢物處理:檢測之后帶菌平板置于121℃下高壓滅菌30分鐘后處理。
上海威生物科技有限公司其他部分產品目錄:
兔凝血酶原片段F1+2(F1+2)ELISA試劑盒 Rabbit prothrombin fragment 1+2,F1+2 ELISA kit 人特異性巨噬細胞武裝因子(SMAF)ELISA試劑盒 Human Specifie Macrophage Arming Paetot,SMAF ELISA kit 人纖溶酶原激活劑(PLGA)ELISA試劑盒 Human plasminogen activator,PLGA ELISA kit 大鼠抗中性粒/中心體抗體(ACA)ELISA試劑盒 Rat anti-centrol and centrosome antibody,ACA ELISA kit 大鼠色素上皮衍生因子(PEDF)ELISA試劑盒 Rat pigment epithelium-derived factor,PEDF ELISA kit 人組蛋白H2b(histon-H2b)ELISA試劑盒 Human histon-H2b ELISA kit 兔子血小板因子4(PF-4/CXCL4)ELISA試劑盒 Rabbit Platelet Factor 4,PF-4 ELISA kit 人β2糖蛋白(β2-GP)ELISA試劑盒 Human beta2 glycoprotein,β2-GP ELISA kit 兔超敏C反應蛋白(hs-CRP)ELISA試劑盒 Rabbit high sensitivity C-Reactive Protein,hs-CRP ELISA kit 人α乳清蛋白(α-La)ELISA試劑盒 Human α Lactalbumin,α-La ELISA kit 大鼠白三烯B4(LTB4)ELISA試劑盒 Rat Leukotriene B4,LT-B4 ELISA kit 小鼠可溶性核因子κB受體活化因子配基(sRANKL)ELISA試劑盒 Mouse soluble receptor activator of nuclear factor-kB ligand,sRANKL ELISA kit 人胃泌素釋放多肽(GRP)ELISA試劑盒 Human gastrin-reliasing peptide,GRP ELISA kit 人低分子量細胞角蛋白(CK-LMW)ELISA試劑盒 Human cytokeratin Low Molecular Weight,CK-LMW ELISA kit 大鼠磷酸化蛋白激酶C(P-PKC)ELISA試劑盒 Rat phospho Protein Kinase C,P-PKC ELISA kit 免責聲明:以上所展示的[瓶 RV肉湯]信息由會員[上海極威生物科技有限公司]自行提供,內容的真實性、準確性和合法性由發(fā)布會員負責。
免責聲明:以上所展示的[瓶 RV肉湯]信息由會員[上海極威生物科技有限公司]自行提供,內容的真實性、準確性和合法性由發(fā)布會員負責。